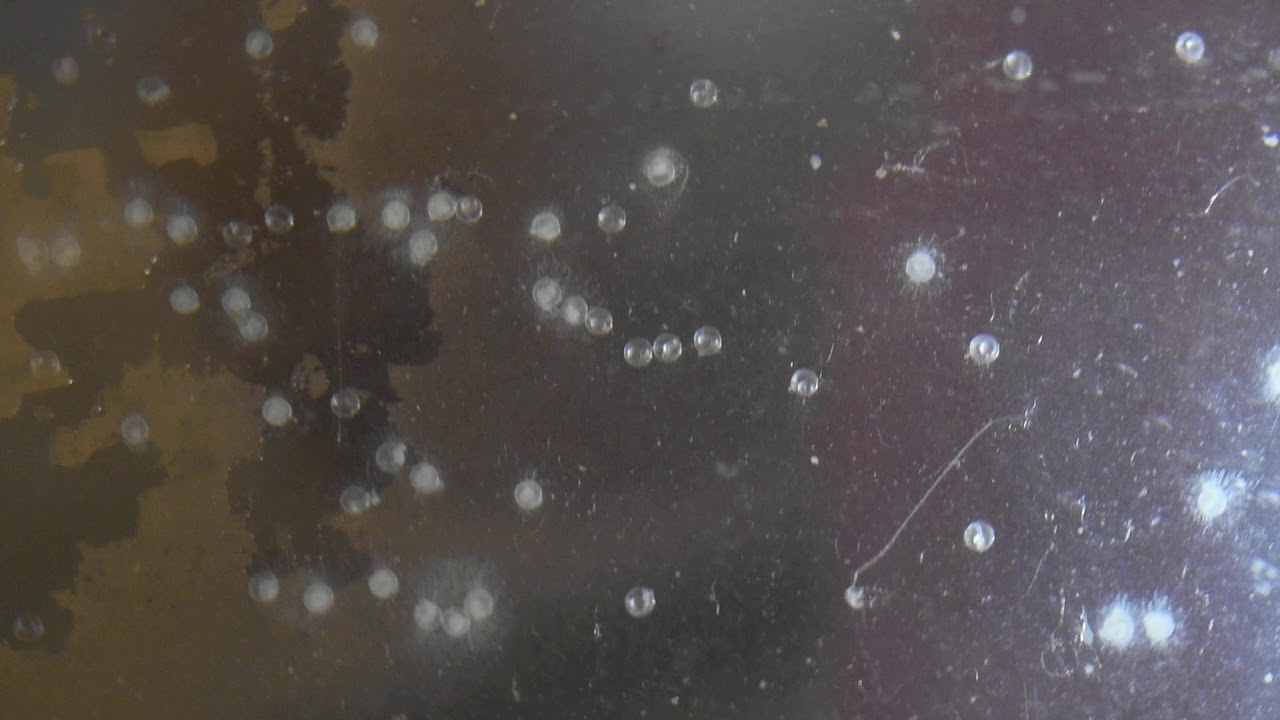
How to tell if zebra danio eggs are fertilized

The pond drys up every year in the dry season. Zebra Danio fish can grow to a maximum size of 5 cm.
How can you tell if a Zebra Danio egg is fertilized.
How to tell if zebra danio eggs are fertilized. If your female zebra danio looks wider than normal there are high chances of pregnancy. However since these fish are not livebearers they do not carry fertilized eggs. They may not become visibly fat so you need to pay close attention.
The best time to figure out if your zebra danio is carrying roe is observing it during the morning. Using coarse gravel will allow the danio eggs to be protected from being eaten by the adults as the eggs can slip between the gravel pieces. How can you tell if a zebra danio egg is fertilized.
A fertilized egg will appear translucent while unfertilized eggs are white. Also an alternative way to finding out if your zebra danios are pregnant is by observing it in the morning. Typically zebra danios spawn in the mornings and so if you find the fish chasing each other during this time then it suggests they are carrying a roe and could be close to spawning.
How Long Does it Take for Zebra Danios to Lay Eggs. Well ive been doing research on this topic and someone told me that maybe the danio is keeping the eggs waiting for them to be fertilized. Theyll keep making more eggs hoping that a male will come along but then after awhile they release them unfertilized.
Im not sure if this was the case with my danio or with fatboys but it sure does. Spawning simply means the female danios have laid eggs and the male danios have fertilized the eggs. Since you cant tell if the eggs are fertilized the best thing to do is watch.
The pond drys up every year in the dry season. 8 months later when the wet season starts the first rain starts some eggs hatching. The species is smart enough that not all the eggs hatch just in case the rain is early and the pond drys up again.
The next lot of eggs hatch later than the first. Egg depositors lay eggs in only one specific spot. Egg scatterers lay sticky or non-adhesive eggs in gravel plants and rocks.
Mouthbrooders fertilized eggs are collected and then carried in the mouth until they hatch. Zebra danios fall into the third category of egg scatterer. Danios are egg layers.
They dont breed until the eggs are laid. She may be full of eggs. If she is she will release them and the male will come along behind and fertilize them.
Its not possible that she mated before you got her and is just now laying eggs. The mating happens after the eggs are laid externally. Firstly a Zebra Danio and simple to breed and are an egg scatters which means they drop there eggs and move on with no caring at all.
Firstly two tanks is a must as the parents or other residents will eat the eggs as they fall and even the fry as they are born. Sexing the mature Zebra Danios is very simple with males being very slIm and females being more heavy when. To be clear zebra danios are not pregnant for any amount of time because they are not livebearers.
They lay their eggs they get fertilized by the male outside of the females body and the fry comes to term and hatch out of those eggs. But the Zebra Danio is probably the easiest egg scattering fish to breed in the home aquarium. So as long as you have both males and females in your tank youre likely to find that the population increases.
Because the Zebra Danio aka Zebrafish is an egg scattering fish it means that the eggs are fertilized externally. How can you tell if a Zebra Danio egg is fertilized. Since you cant tell if the eggs are fertilized the best thing to do is watch for eggs at the bottom of the tank.
Once you see eggs you know your danios have spawned and you can move the adults back to their regular tanks. Can you tell if a fish is pregnant. A zebra danio is ready to lay eggs when you see her midsection bulging with lots of little circular protrusions.
They will get very large and chunky. When the male starts chasing the female a lot it also usually signifies that the female is ready to lay eggs. Look at your female danio.
If she looks wider than normal she is probably carrying roe. Since danios are not livebearers and female danios never carry fertilized eggs this is as close as danios get to being pregnant. If your female is carrying roe your male danio will fertilize the eggs as they are dropped during spawning.
1- Place a coarse plastic mesh inside the breeding tank and the water level in the tank is adjusted so that the fish have about 5 centimetres to swim in. Httpamznto2DJ6kojSee zebra danio eggs developing and hatching under a microscopeAlso view very active beneficia. Zebrafish lay eggs which are fertilized by the male after they are laid.
After they lay the eggs they will tend to eat them so if you want to keep the eggs you should either have something like marbles rods plants or a mesh in the tank that the eggs will sink into and that will keep the fish away from the eggs. Zebra danios Danio rerio formerly Brachydanio rerio scatter nonadhesive eggs amid plant leaves and substrate. The breeders quickly revert to eating the eggs however so a hobbyist who wants success breeding these fish needs to take precautions to protect the eggs.
Breed Zebra Danios. -Zebrafish are one of the easiest egg laying fish that you can pair on your ownNowwhat you need is a 2-3 male danios and 1 female danio witch is full with eggsYou can see which one is male and which one is female by the bellythe female ones are much fatter because they are usually filled with eggsand the male danios are. Zebra danios can lay eggs every few days when the tank conditions are suitable.
GloFish danios like to breed in spawns this means that they do it in groups rather than having just one male with one femaleThe female fish will deposit her eggs and. Zebra Danio fish come from Myanmar India and Sri Lanka. Zebra Danio fish can grow to a maximum size of 5 cm.
This fish is included into the type of omnivorous fish. In maintenance in water tanks both in fish ponds or in aquariums water quality needs to be considered Zebra Danio fish can live optimally at temperatures of 25-27 C pH 65-7 and water.